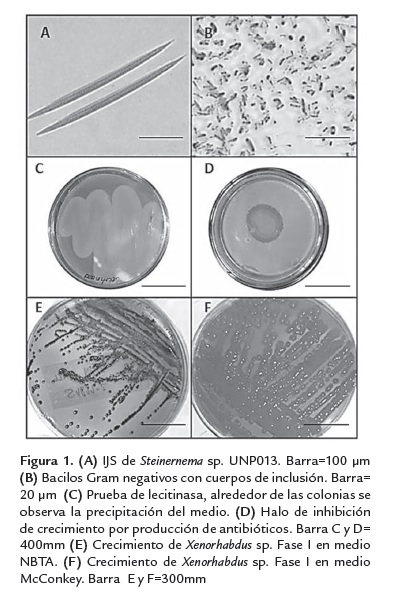

Services on Demand
Journal
Article
Indicators
-
Cited by SciELO -
Access statistics
Related links
-
Cited by Google -
Similars in
SciELO -
Similars in Google
Share
Revista Colombiana de Biotecnología
Print version ISSN 0123-3475
Rev. colomb. biotecnol vol.16 no.1 Bogotá Jan./June 2014
https://doi.org/10.15446/rev.colomb.biote.v16n1.44277
http://dx.doi.org/10.15446/rev.colomb.biote.v16n1.44277
ARTÍCULO DE INVESTIGACIÓN
Evaluación de la patogenicidad de Xenorhabdus spp. nativos en Colombia
Evaluation of pathogenicity Xenorhabdus spp. natives in Colombia
Titulo corto: Xenorhabdus spp: Patogenicidad
Beatriz Elena Guerra S.1, Julie Giovanna Chacón2, Jaime Eduardo Muñoz F.3 y Ana Milena Caicedo4.
1 PhD(c). Laboratorio de innovación e investigación en biotecnología agroambiental, Grupo Microbiota- Universidad de Santander, Bucaramanga, Colombia-bguerra@udes.edu.co
2 Microbióloga Industrial, Laboratorio de innovación e investigación en biotecnología agroambiental, Grupo Microbiota- Universidad de Santander, Campus Universitario lagos del cacique- bloque Guane, Bucaramanga, Colombia.juliechao@msn.com
3 Ph.D. Grupo de Investigación en Diversidad Biológica Universidad Nacional de Colombia Sede Palmira Colombia. jemunozf@palmira.unal.edu.co
4 Ph.D. Grupo de Investigación en Diversidad Biológica Universidad Nacional de Colombia Sede Palmira Colombia. anam.caicedo@gmail.com
Recibido: septiembre 23 de 2013 Aprobado: abril 25 de 2014
Resumen
Las bacterias Xenorhabdus y Photorhabdus están asociadas simbióticamente con nematodos de las familias Steinernematidae y Heterorhabditidae respectivamente. Se caracterizan por producir un complejo de sustancias como toxinas, antibióticos y enzimas extracelulares que matan los insectos. Con el objetivo de seleccionar los nematodos más patogénicos y su nivel de producción de antibióticos se propuso evaluar la patogenicidad de 13 aislamientos nativos. Las bacterias se aislaron de juveniles infectivos (JIS) por macerado directo, se cultivaron en medios microbiológicos selectivos (NBTA y MacConkey) y se describieron fenotípica y bioquímicamente. La patogenicidad se evaluó en larvas de último instar de G. mellonella L. (Lepidóptera: Pyralidae), mediante diluciones seriadas de inóculo bacteriano con una concentración de 104cel/ml. Se registró el porcentaje de mortalidad a las 12, 24 y 48 horas y las unidades formadoras de colonia (UFC) en agar NBTA, en los mismos intervalos de tiempo. Los datos se sometieron a un análisis de varianza y a la prueba de comparación de medias de Duncan. Las pruebas bioquímicas y enzimáticas resultaron positivas para el género Xenorhabdus. Los análisis estadísticos mostraron que los aislamientos, UNPX04, UNPX15 provenientes de La Florida-Risaralda y Llano Bajo-Valle del Cauca respectivamente, causaron el 100 % de mortalidad a las 12 y 24 horas en contraste con siete aislamientos que causaron sólo el 70% de mortalidad.
Palabras clave:antibióticos, manejo, steinernema, virulencia
Abstract
Xenorhabdus and Photorhabdus bacteria are symbiotically associated with nematodes of the families Steinernematidae and Heterorhabditidae respectively. They are characterized by producing a complex of substances such as toxins, antibiotics and extracellular enzymes that kill insects. In order to select the most pathogenic nematodes and antibiotic production level, it was propose to evaluate the pathogenicity of 13 native isolates. Bacteria were isolated from infective juveniles (JIS) by direct macerated, cultured on selective media (NBTA and MacConkey) and described phenotypic and biochemically. The pathogenicity was evaluated on the last instar larvae of G. mellonella, using serial dilutions of the bacterial inoculum with a concentration of 104cel/ml. The mortality rate was registered at 12, 24 and 48 hours and the colony forming units (CFU) in NBTA agar in the same intervals of time. The data were analyzed by variance analysis and mean comparison by Duncan test. Biochemical and enzymatic tests were positive for the genus Xenorhabdus. The results showed that the isolates UNPX04, UNPX15 from agricultural soils of Florida -Risaralda and Llano Bajo- Valle del Cauca respectively, caused 100% of mortality at 12 and 24 hours in contrast with seven isolations that caused only 70% of mortality.
Key words: antibiotics, management, steinernema, virulence.
Introducción
Los Nematodos (entomopatógenos (Neps) de los géneros Steinernema y Heterorhabditis son utilizados para el manejo de un amplio rango de especies de insectos-plaga de importancia agrícola (Hazir et al., 2003). El mecanismo por el cual estos organismos infectan y se reproducen en los insectos hospederos involucra una relación mutualística entre el nematodo y las bacterias simbióticas Xenorhabdus spp y Photorhabdus spp. (Akhurst y Dunphy, 1993; Forst y Nealson, 1996; Adams et al., 2006; Chaston et al., 2011). Las bacterias se caracterizan por ser Gram-negativas, anaerobias facultativas, no forman espora, presentan numerosos pelos flagelares y sólo se recuperan de los infectivos juveniles (IJS) o de hospederos infectados (Akhurst y Boemare, 1990; Hinchliffe et al., 2010).
Además de ser patógenas a insectos (Boemare y Akhurst, 1988; Burnell y Stock, 2000; Hinchliffe et al., 2010), producen metabolitos antimicrobianos (Webster et al., 1998), antibióticos de bajo peso molecular y enzimas extracelulares como proteasas, lipasas, fosfolipasas y DNAasas. Estos compuestos están involucrados en la destrucción de tejidos de insectos que son utilizados como alimento para los nematodos (Forst y Nealson, 1996; Adams et al., 2006; Hincliffe et al., 2010).
El rango de actividad antibiótica es variable y depende de la especie bacteriana y de la fase de desarrollo (Akhurst 1982). Aunque los IJS juegan un papel importante en la muerte del insecto al transportar la bacteria, la cual es suficiente para causar mortalidad cuando es inyectada al hemocele del insecto (Gotz et al.,1981).
Estudios realizados han demostrado que la suspensión bacteriana es tóxica a especies de insectos como la hormiga de fuego, Solenopsis invicta, asperjadas sobre hojas de algodón (Dudney 1997) y sobre larvas y pupas de Spodoptera exigua (Elawad et al., 1999). Asimismo, la aplicación de células en solución y el filtrado bacterial de Xenorhabdus nematophila en suspensión acuosa fue letal a las larvas de Plutella xylostella. Su aplicación sobre hojas de Brassica oleracea var. Chinese mostraron que las células pueden penetrar en los insectos en ausencia del nematodo. Las soluciones libres de células bacteriales que contenían los metabolitos también fueron efectivas, lo cual representa una posible estrategia para el control de insectos sobre el follaje (Mahar et al., 2004).
De igual manera, Yi y Ehlers (2006) evaluaron el potencial de la aplicación de Bacillus thuringiensis en mezcla con X. nematophila sobre larvas de tercer instar de P. xyllostella. Se considera que los patógenos de insectos son una fuente de nuevos agentes insecticidas que proporcionan toxicidad. Especialmente las bacterias de los géneros Xenorhabdus y Photorhabdus son consideradas como una mina de oro, que codifican una multitud de toxinas insecticidas. Algunas altamente específicas a determinadas especies de insectos y otras más generalistas, pero con gran potencial de uso en la protección de cultivos. Además, estas bacterias están equipadas para producir un vasto rango de compuestos antimicrobiales los cuales también podrían usarse en la ciencia médica (Bowen y Ensign, 1998; Ffrench y Bowen, 1999; Ensigne et al., 2002; Hinchliffe et al., 2010).
Considerando el potencial bio-controlador de estas bacterias, se propuso caracterizar morfológica y bioquímicamente aislamientos nativos obtenidos de suelos dedicados al cultivo de Bactris gasipaes K, chontaduro y en guaduales, Guadua angustifolia Kunth. Así mismo, evaluar su patogenicidad sobre larvas de G. mellonella, (insecto hospedante de fácil manejo y reproducción) como una preselección in vitro del potencial que permita su implementación en opciones de manejo de insectos-plaga en nuestro país.
Materiales y métodos
Nematodos entomopatógenos
Los 13 aislamientos de Neps fueron reactivados del cepario del laboratorio de biología molecular de la Universidad Nacional de Colombia, sede Palmira que se encuentra a 4 ° C, la procedencia de cada aislamiento se presenta en la tabla 1. Para su reactivación se utilizaron larvas de último instar de G. mellonella (insecto sobre el cual está estandarizado la producción in vivo y sobre las larvas de último instar por su mayor tamaño, lo cual garantiza una mayor producción de neps). La reactivación se realizó de acuerdo a la metodología de Kaya y Stock (1997). Cada aislamiento se inoculó sobre 20 larvas de G. mellonella con una solución de 200 IJS/ml en cajas Petri de 100 mm y papel toalla estéril mantenidas en oscuridad durante 7-10 días con condiciones de 23 °C±3 de temperatura y 65% ± Humedad Relativa (HR). Los IJS se recuperaron de las trampas White y se almacenaron en agua destilada estéril a 4°C durante 7 días antes de iniciar el proceso de aislamiento de las bacterias.
Aislamiento y purificación bacteriana
Las bacterias se aislaron mediante la técnica modificada de macerado de IJS (Boemare et al.,1997), la cual consistió en la desinfección de 100 IJS por inmersión en una solución de hipoclorito de Sodio (NaClO) al 3% , durante 3±1 min , seguido de tres enjuagues con agua destilada estéril. Posteriormente, 40 IJS se adicionaron en una gota de hemolinfa de G. mellonella. Se maceraron con un pistilo estéril y se sembraron 100 µl en agar NBTA (Agar Nutritivo; 25 mg Azul de Bromotimol; 40 mg Cloruro de TrifenilTetrazolium; 1000 ml agua destilada), y se incubaron en la oscuridad a 28 °C durante 72 h.
Caracterización fenotípica y bioquímica de las bacterias
La caracterización fenotípica de la forma primaria de las bacterias, se realizó con tinción de Gram, pruebas bioquímicas de motilidad, actividad proteasa, lipasa y lecitinasa, producción de antibióticos y la detección de la bioluminiscencia sugeridas por Boemare et al. (1997) y Arkhurst (1980). Adicionalmente, se realizaron siembras por estrías en medio McConkey para observar la capacidad de absorción del rojo neutro. La absorción de Azul de Bromotimol y la reducción del Cloruro deTrifenil-Tetrazolium se evaluó en medio NBTA (Boemare et al., 1997).
La prueba de motilidad se evaluó en medio semisólido, para determinar la presencia de flagelos. La actividad proteasa en agar-gelatina, la actividad lipasa en Tween 80, la lecitinasa en agar nutritivo suplementado con yema de huevo al 10%, la luminiscencia se determinó por observación de las colonias en agar nutritivo en un cuarto oscuro por 10 minutos y la producción de antibióticos se evaluó por la medición del halo de inhibición de crecimiento frente a B. thuringiensis (suministrada como cepa en crecimiento en caja Petri, no en formulación comercial, por la empresa Bioecológicos del Valle del Cauca).
Evaluación de la patogenicidad
Se inocularon larvas de último instar de G. mellonella con una jeringa de insulina cargada con 10 µl de solución de cada aislamiento bacteriano con una concentración de 104cel/ml. La inoculación se realizó a la altura del último par de patas. Las larvas se individualizaron en vasos plásticos de 4 onzas. La mortalidad se registró a las 12, 24 y 48 h después de inoculadas. El diseño experimental fue de tipo factorial, con seis larvas por unidad experimental y cinco repeticiones en el tiempo (6 larvas x 14 tratamientos (13 aislamientos y el control) x 3 tiempos y 5 repeticiones= 1260). El control se inoculó con 10 µl de solución Ringer (9 g NaCl, 0.4 g KCl, 0.4 g CaCl2 , 0.2 g NaH2CO3 en un litro de agua) (Kaya y Stock, 1997).
El crecimiento bacteriano dentro de la larva se evaluó en términos de UFC, sembrando una gota de hemolinfa de larvas (previamente desinfectadas en Hipoclorito al 3%, durante 3 min) en medio NBTA a las 12, 24 y 48 h, después de la inoculación. El diseño experimental y los tratamientos fue igual al del ensayo anterior.
Análisis estadístico
Los datos se sometieron a un análisis de varianza y a la prueba de comparación de medias de Duncan. Se analizó la interacción entre: (i) los 13 aislamientos bacterianos y los tres tiempos con la mortalidad de larvas; (ii) los 13 aislamientos bacterianos y los tres tiempos evaluados en la curva de crecimiento bacteriano.
Resultados y discusión
Los trece aislamientos bacterianos presentaron los principales rasgos fenotípicos descritos para el género Xenorhabdus (Akhurst y Boemare, 2005) de la familia Enterobacteriaceae. Los miembros de esta familia son bacilos Gram-negativos anaerobios facultativos, negativos para oxidasa, no forman esporas, heterótrofos quimiorgánicos con metabolismo fermentativo y respiratorio y con la excepción de unos pocos miembros, son motiles por flagelos perítricos (Brenner, 1999). Xenorhabdus y Photorhabdus son típicos de la familia Enterobacteriaceae y ningún otro miembro de esta familia es fenotípicamente similar (Holt et al., 1994). Por ejemplo, Xenorhabdus es negativo para catalasa, similar solamente a Shigella dysenteriae y la mayoría de Xenorhabdus y Photorhabdus son negativos para nitrato reductasa, característica compartida solamente con algunas cepas de Erwinia y Yersinia (Boemare, 2002; Brenner, 1999). La diferencia más marcada entre los dos géneros es que la mayoría de los aislamientos de Photorhabdus son bioluminicentes y catalasa positivos mientras que Xenorhabdus son negativos para ambas características (Forst et al., 1997). Ambos géneros producen formas fenotípicas variables. La forma primaria o fase I es la forma naturalmente asociada con los nematodos, mientras que la forma secundaria o fase II puede aparecer espontáneamente cuando la bacteria está en cultivo. Las diferencias entre las fases son que en fase I la bacteria produce antibióticos, adsorbe ciertos colorantes y tiene inclusiones intracelulares compuestos de proteínas cristalinas, mientras que la fase II, no adsorbe colorantes, no produce antibióticos y produce inclusiones intracelulares ineficientemente. La forma de la colonia son diferentes y la diferencia en patogenicidad se ha observado sobre algunos hospederos (Volgyi et al., 1998; Adams et al., 2006; Thomas y Poinar, 1979), lo que demuestra su relación con los Neps del género Steinernema (figura 1A).
Las células bacterianas aisladas mostraron movilidad en las pruebas de agar semisólido y al exámen microscópico se identificaron como bacilos Gram negativos con cuerpos de inclusión (figura 1B). Las prueba lipasa, lecitinasa (figura 1C) y proteasa fueron positivas para todos los aislamientos.
Los aislamientos mostraron la capacidad de producir antibiótico para inhibir el crecimiento de B. thuringiensis (figura 1D), mostrando diferencias en los diámetros de los halos de inhibición de crecimiento. La luminiscencia fue negativa para todos los aislamientos (tabla 2) del género Steinernema sólo las bacterias del género Photorhabdus son las únicas bacterias terrestres bio-luminiscentes.
Las colonias en medio NBTA (figura 1E) mostraron una coloración azul (Fase I), por absorción del Azul de Bromotimol, a excepción del aislamiento UNPX12 cuya coloración fue verde-azulada, lo cual de acuerdo a Kaya y Stock (1997) depende de la especie bacteriana. La forma de las colonias para todos los aislamientos fue redondeada, convexa, con borde definido, de color claro y 2 mm de diámetro aproximadamente (figura 1F). En medio McConkey las colonias presentaron un tamaño de 4 mm de diámetro y se evidenció la absorción del Rojo Neutro y fermentación de la Lactosa, por la coloración rojiza de las colonias y viraje del medio. El crecimiento de las colonias fue lento, se observó crecimiento de colonias a partir de 72 h, en todos los medios evaluados. Esta descripción concuerda con los resultados encontrados por Campos et al. (2009) donde todos los aislamientos obtenidos a partir del macerado de IJS de Neps mostraron coloración azul por absorción de pigmentos del medio, pero contrasta con lo reportado por Gerritsen et al. (1992) en la obtención de colonias rojas de Xenorhabdus spp. pertenecientes a formas variantes de la fase primaria.
La mortalidad de larvas de G. mellonella en el tiempo y entre aislamientos, fue analizada mediante la prueba de Duncan (tabla 3), resultando significativamente diferente (p<0.05) y se incrementó con el paso del tiempo de una manera diferencial en cada aislamiento, como se observa en la figura 2.
El máximo porcentaje de mortalidad en el menor tiempo se logró con los aislamientos UNPX04 y UNPX15 (figura 2), las cuales empezaron a causar la muerte en larvas de G. mellonella por septicemia a partir de 12h después de la inoculación, ambas con un número de UFC superior a 106cell/ml. A pesar que otros aislamientos presentaron similitud en el número de UFC, no presentaron virulencia a las 12 h (tabla 4). Siete de los 13 aislamientos mostraron porcentaje de mortalidad mayor del 70% a las 24 h de inoculación, lo cual contrasta con lo obtenido por Campos et al. (2009) al evaluar X. bovienii ES14 aplicando el doble del volumen (20 µl) y la misma concentración sobre larvas de S. littoralis, alcanzando una mortalidad del 80% a las 24 h. Los resultados contrastan con los obtenidos por Mahar et al. (2005) quienes obtuvieron una mortalidad del 93% de G. mellonella con inoculaciones de X. nematophila a una concentración de 4x107 cel/ml comparado con el 100% de mortalidad obtenido con los aislamientos nativos de UNPX04 de la Florida, Risaralda y UNPX15 de Llano Bajo, Valle del Cauca con una concentración de 104cel/ml, sugiriendo que estos aislamientos son altamente virulentos.
Las UFC en tiempo y entre aislamientos fueron significativamente diferentes (P<0.05), como se observa en la figura 3, debido a que no todas las especies desarrollan los mismos factores de virulencia (toxinas) para evadir el sistema inmune del insecto hospedero.
En general el aumento de UFC se observa entre las 12 y 24 h después de la inoculación como lo describe Sicard et al. (2004). El crecimiento exponencial retrasado de los aislamientos posiblemente se deba a que las bacterias quedan atrapadas en los hemocitos, donde se multiplican lo suficiente para después pasar al hemocele
Se encontraron diferencias entre los aislamientos así: en los aislamientos UNPX01, UNPX04, UNPX06, UNPX09, UNPX10, UNPX12 y UNPX15 la septicemia se produjo antes de la muerte de las larvas, mientras que en los aislamientos UNPX02, UNPX03, UNPX07, UNPX08, UNPX12, y UNPX13 la mortalidad de la larva ocurrió cuando el crecimiento bacteriano se encontraba en el pico de la fase estacionaria, como lo mencionan Clarke y Dowds (1995).
El mayor porcentaje de mortalidad de G. mellonella inoculada con los aislamientos bacterianos se observa a las 48h, debido a que la mayoría de aislamientos empezaron a morir a partir de las 24h (figura 2).
La identificación molecular de las especies bacterianas, hace parte de la continuación de este trabajo (dato no publicado).
Conclusiones
De las 13 cepas de Neps, se aislaron y caracterizaron bacterias del género Xenorhabdus en fase I. Las diferencias significativas encontradas entre los aislamiento en las pruebas de porcentaje de mortalidad y UFC hacen suponer que los aislamientos pertenecen a diferentes especies, o entre la misma especie existe variabilidad genética. El porcentaje de mortalidad, no siempre es directamente proporcional al número de bacterias presentes en la larva, pues pueden encontrarse ciertas especies donde un bajo número de bacterias puede causar la muerte de los insectos. Siendo estos aislamientos más virulentos, que los asilamientos bacterianos que necesitan una mayor población para causar septicemia. Los resultados obtenidos permiten considerar las bacterias simbiontes de Neps como alternativa viable para el manejo integrado de insectos plaga y su uso en el desarrollo de producción masiva de Neps tanto en medio sólido como in vitro.
Referencias bibliográficas
1 Adams BJ., Fodor A., Koppenhöfer HS., Stackebrandt E., Stock SP.,Klein MG. 2006. Biodiversity and systematics of nematode-bacteriumentomopathogens. Biological Control. 38:4-21. [ Links ]
2 Arkhurst R. 1980. Morphological and functional dimorphism in Xenorhabdus spp., bacteria symbiotically associated with the insect pathogenic nematodes Neoaplectana and Heterorhabditis. Journal of genetic Microbiology. 121: 303-309. [ Links ]
3 Akhurst R. 1982. Antibiotic activity of Xenorhabdus spp., bacteria symbiotically associated with insect pathogenic nematodes of the families Steinernematidae and Heterorhabditidae. Journal of genetic Microbiology. 128: 3061-3065. [ Links ]
4 Akhurst R., Boemare N. 1990. Biology and taxonomy of Xenorhabdus. Entomopathogenic nematodes in biological control. Boca Raton, FL .Gaugler,R., Kaya H. 75-90. [ Links ]
5 Akhurst R, Boemare N. 2005. Genus XL. Xenorhabdus. Bergey's Manual of Systematic Bacteriology, (The Proteobacteria), Part B (The Gammaproteobacteria). New York. In: Brenner, D.J., Krieg, N.R., Staley, J.T., Garrity, G.M.Springer. 2: 831-838. [ Links ]
6 Akhurst R., Dunphy G. 1993. Tripartite interaction between symbiotically associated entomopathogenic bacteria, nematodes and their insect hosts. Parasites and Pathogen of Insects. 2: 1-23. [ Links ]
7 Boemare N., Akurst R. 1988. Biochemical and Physiological Characterization of Colony form Variants in Xenorhabdus spp. (Enterobactereaceae). International Journal of Systematic Bacteriology. 134: 751-761. [ Links ]
8 Boemare N., Givaudan A., Brehelin M., Laumond C. 1997. Symbiosis and pathogencity of nematode bacterium complexes. Symbiosis. 22: 21-45. [ Links ]
9 Bowen D., Ensign J. 1998. Purification and characterization of a high-molecular-weight insecticidal protein complex produced by the entomopathogenic bacterium Photorhabdus luminescens. Applied and Environmental Microbiology. 64: 3029-3035. [ Links ]
10 Burnell A., Stock S. 2000. Symposium Heterorhabditis, Steinernemaand their bacterial symbionts -lethal pathogens of insects. Nematology. 2(1): 31-42. [ Links ]
11 Chaston JM., Suen G., Tucker SL., Andersen AW., Bhasin A,. 2011. The Entomopathogenic Bacterial Endosymbionts Xenorhabdus and Photorhabdus: Convergent Lifestyles from Divergent Genomes. PLoS ONE. 6(11): e27909. doi:10.1371/journal.pone.0027909 [ Links ]
12 Campos R.,Tailliez P.,Pages S., Ginibre N., Gutierrez C., Boemare N. 2009. Characterization of Xenorhabdus isolates from La Rioja (Northern Spain) and virulence with and without their symbiotic entomopathogenic nematodes (Nematoda: Steinernematidae). Journal of Invertebrate Pathology. 102(2): 173-181. [ Links ]
13 Clarke D., Dowds B. 1995. Virulence mechanisms of Photorhabdus sp. Strain K122 toward wax moth larvae. Journal of Invertebrate Pathology. 66: 149-155. [ Links ]
14 Dudney R. 1997. Use ofXenorhabdus nematophilusIm/l and 1906/1 for Fire Ant Control. US Patent Application 5616 318. [ Links ]
15 Elawad S., Gowen S., Hague N. 1999. Efficacy of bacterial symbionts from entomopathogenic nematodes against the beet army worm (Spodoptera exigua).Test of Agrochemicals and Cultivars No. 20. Annals of Applied Biology.134: 66-67. [ Links ]
16 Ensign J., Bowen D., Tenor J., Ciche T., Petell J., Strickland J., Orr G., Fatig R., Bintrim S., Ffrench-Constant R. 2002. Proteins from the genus Xenorhabdus are toxic to insects on oral exposure. US Patent Application. 20020147148. [ Links ]
17 Ffrench-Constant R., Bowen D. 1999. Photorhabus toxins: novel biological insecticides. Current Opinion in Microbiology. 2: 284-288. [ Links ]
18 Forts S., Nelson K. 1996. Molecular Biology of the Symbiotic-Pathogenic Bacteria Xenorhabdus spp. and Photorhabdus spp. Microbiological reviews. 60( 1): 21-43. [ Links ]
19 Gerritsen L., De Raay G., Smit P. 1992. Characterization of form variants of Xenorhabdus luminescens. Applied and Environmental Microbiology. 58(6): 1975-1979. [ Links ]
20 Gotz P., Boman A., Boman H. 1981. Interactions between insect immunity and insect pathogenic nematode with symbiotic bacteria. Proceedings of the Royal Society of London. 212: 333-350. [ Links ]
21 Hazir S., Kaya H., Stock P., Keskün N. 2003. Entomopathogenic Nematodes (Steinernematidae and Heterorhabditidae) for Biological Control of Soil Pests. Turkish Journal of Biology. 27: 181-202. [ Links ]
22 Hinchliffe SJ., Hares MC., Dowling AJ. and ffrench-Constant RH. 2010. Insecticidal Toxins from the Photorhabdus and Xenorhabdus Bacteria The Open Toxicology Journal, 3: 101-118. [ Links ]
23 Kaya H., Stock S. 1997. Manual of techniques in insect pathology.Biological techniques.Academic Press, Inc. San Diego. En: Lacey, L. A. 281-324. [ Links ]
24 Mahar AN., Munir M., Elawad S., Gowen S R., Hague N G. 2004. Microbial control of diamondback moth, Plutella xylostella L. (Lepidoptera: Yponomeutidae) using bacteria (Xenorhabdus nematophila) and its metabolites from the entomopathogenic nematode Steinernema carpocapsae. J Zhejiang Univ. SCI. 5(10):1183-1190. [ Links ]
25 Mahar A., Munir M., Gowen S., Hague N. 2005. Role of entomopathogenic bacteria, Photorhabdus luminescens and its toxic secretions against Galleria mellonella larvae. Journal of Entomology. 2: 69-76. [ Links ]
26 Sicard M., Brugirard-Ricaud K., Pagès S., Lanois A., Boemare N.,Brehélin M.,Givaudan A. 2004. Stage of infection during the tripartite interaction between Xenorhabdus nematophila, its nematode vector and the insect hosts. Application Environmental Microbiology. 70: 6473-6480. [ Links ]
27 Thomas G., Poinar G. 1979. Xenorhabdus gen. nov., a genus of entomopathogenic and nematophilic bacteria of the family Enterobacteriaceae. International Journal of Systematic Bacteriology. 29:352-360. [ Links ]
28 Webster J., Chen G., Li J. 1998. Parasitic worms. An ally in the war against the superbugs. Parasite Today. 14: 161-163. [ Links ]
29 Yi X., Ehlers R. 2006. Combining Steinernemacarpocapsae and Bacillus thuringienis strains for control of diamondback moth (Plutellaxylostella). Communications in agricultural and applied biological sciences. 71(3):633-6. [ Links ]